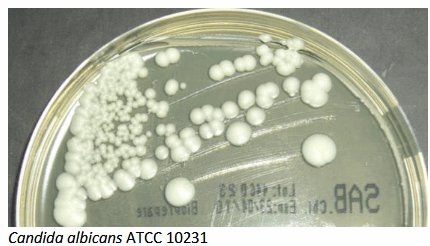

- Δίσκοι ευαισθησίας
- Προϊόντα ταυτοποίησης
- Χρωστικές
- Αναλώσιμα εργαστηρίου
- Αναλώσιμα αναλυτών
- Σωληνάρια αιμοληψιών
- Σωληνάρια αιμοληψιών κενού
- Σωληνάρια πλαστικά – πώματα
- Σύριγγες – βελόνες – πεταλούδες
- Αντικειμενοφόρες πλάκες – καλυπτρίδες – μικροαιματοκρίτες
- Πιπέτες Pasteur
- Πιπέτες Καθίζησης – Στατώ Καθίζησης
- Ρύγχη
- Τρυβλία
- Στυλεοί – κρικοφόροι
- Διαλύματα γλυκόζης
- Λάστιχο αιμοληψίας
- Παραφίλμ
- Strips
- Βαμβάκι
- Δοχεία απόρριψης βελονών
- Ουροδοχεία
- Θρεπτικά Υλικά
- Διάφορα αντιδραστήρια
- The quantity must be a multiple of 10.
Σύριγγες πλαστικές BMDI Weigao Group, με βελόνα,τριών μερών luer slip.
Σύριγγα BMDI με Βελόνα, αποστειρωμένη, μιας χρήσης. Διάφανο πολυπροπυλένιο, μη τοξικό και μη πυρετογόνο. Ατομική συσκευασία σε blister. Latex free.
ℹ️ Ελάχιστη Παραγγελία: 100 τεμ.( 2.5ml – 5ml – 10ml )
ℹ️ Ελάχιστη Παραγγελία: 50 τεμ.(20ml)
ℹ️ Το προιόν διατίθεται σε : 2.5ml , 5ml, 10ml, 20ml.
Κωδικός προϊόντος:
061.04.
Κατηγορίες: Αναλώσιμα εργαστηρίου, ΜΙΚΡΟΒΙΟΛΟΓΙΚΑ, ΝΟΣΟΚΟΜΕΙΑΚΑ ΕΙΔΗ, Σύριγγες, Σύριγγες – βελόνες - πεταλούδες
Ετικέτα: ΣΥΡΙΓΓΕΣ ΧΩΡΙΣ ΒΕΛΟΝΑ
Περιγραφή
Σύριγγα BMDI με βελόνα αποστειρωμένη, μιας χρήσης. Διάφανο πολυπροπυλένιο, μη τοξικό και μη πυρετογόνο. Ατομική συσκευασία σε blister. Latex free.
⚠️ Οι τελικές τιμές επιβεβαιώνονται με την λήψη του προτιμολογίου και ενδέχεται να αλλάξουν χωρίς ειδοποίηση.
⚠️ Οι φωτογραφίες έχουν αποκλειστικά ενδεικτικό χαρακτήρα & ενδέχεται να διαφέρoυν από το πραγματικό προϊόν.
Μεταφορικά
Για τα μεταφορικά επικοινωνήστε μαζί μας
Επικοινωνια
Σχετικά προϊόντα
MAC CONKEY AGAR No2 BIOPREPARE Φιαλίδιο 100 ml
Για την καλλιέργεια και ταυτοποίηση των εντεροβακτηριδίων και του Εντερόκοκκου.
ℹ️ Ελάχιστη Παραγγελία: 10 x 100 ml ℹ️ Συσκευασία: 10 x 100 ml
⚠️ Οι τελικές τιμές επιβεβαιώνονται με την λήψη του προτιμολογίου και ενδέχεται να αλλάξουν χωρίς ειδοποίηση. ⚠️ Οι φωτογραφίες έχουν αποκλειστικά ενδεικτικό χαρακτήρα & ενδέχεται να διαφέρoυν από το πραγματικό προϊόν.
MUELLER HINTON AGAR BIOPREPARE Τρυβλίο 90 mm
Ένα μέσο για την αντιμικροβιακή δοκιμή ευαισθησίας στα αντιβιοτικά με τη μέθοδο διάχυσης του αντιβιοτικού από περιοχή μεγαλύτερης πυκνότητας σε περιοχή μικρότερης πυκνότητας (ζώνη αναστολής ανάπτυξης του μικροβίου).
ℹ️ ΧΡΟΝΟΣ ΖΩΗΣ: 150 ημέρες ℹ️ ΦΥΛΑΞΗ : 2 – 8* C
ℹ️ Ελάχιστη Παραγγελία: 10 x 90 mm ℹ️ Συσκευασία: 10 x 90 mm
⚠️Οι τελικές τιμές επιβεβαιώνονται με την λήψη του προτιμολογίου και ενδέχεται να αλλάξουν χωρίς ειδοποίηση. ⚠️Οι φωτογραφίες έχουν αποκλειστικά ενδεικτικό χαρακτήρα & ενδέχεται να διαφέρoυν από το πραγματικό προϊόν.
MycoTest ST BIOPREPARE 6 x 1,2ml 10 test
Το Mycotest ST χρησιμοποιείται για τον έλεγχο ευαισθησίας των M. Hominis (Mh) και U. urealyticum (Uu) σε έξι αντιβιοτικά (LINCOMYCIN, ROXITHROMYCIN, DOXYCYCLINE, OFLOXACIN, AZITHROMYCIN, LEVOFLOXACIN).
Με την παράλληλη χρήση του Mycotest και του Mycotest Agar μας δίνεται η δυνατότητα ταυτοποίησης και αριθμητικής εκτίμησης. Τα τρία προϊόντα ενώνονται μεταξύ τους και σχηματίζουν ένα ενιαίο κιτ για την πλήρη διάγνωση των Mh και Uu.
ℹ️ Συσκευασία: 10 Σωληνάρια (6 x 1,2ml)
⚠️Οι τελικές τιμές επιβεβαιώνονται με την λήψη του προτιμολογίου και ενδέχεται να αλλάξουν χωρίς ειδοποίηση. ⚠️Οι φωτογραφίες έχουν αποκλειστικά ενδεικτικό χαρακτήρα & ενδέχεται να διαφέρoυν από το πραγματικό προϊόν.
SABOURAUD DEXTROSE AGAR W/ CHLORAMPHENICOL BIOPREPARE Φιαλίδιο 100 ml
Το SABOURAUD DEXTROSE AGAR W/ CHLORAMPHENICOL είναι ένα υλικό που χρησιμοποιείται για την απομόνωση, καλλιέργεια και ταυτοποίηση παθογόνων και μη παθογόνων μυκήτων.
ℹ️ ΧΡΟΝΟΣ ΖΩΗΣ: 365 ημέρες ℹ️ ΦΥΛΑΞΗ : 2 – 25* C
ℹ️ Ελάχιστη Παραγγελία: 10 x 100 ml ℹ️ Συσκευασία: 10 x 100 ml
⚠️ Οι τελικές τιμές επιβεβαιώνονται με την λήψη του προτιμολογίου και ενδέχεται να αλλάξουν χωρίς ειδοποίηση. ⚠️ Οι φωτογραφίες έχουν αποκλειστικά ενδεικτικό χαρακτήρα & ενδέχεται να διαφέρoυν από το πραγματικό προϊόν.
SABOURAUD DEXTROSE AGAR W/ CHLORAMPHENICOL BIOPREPARE Τρυβλίο 60mm
Το SABOURAUD DEXTROSE AGAR W/ CHLORAMPHENICOL είναι ένα υλικό που χρησιμοποιείται για την απομόνωση, καλλιέργεια και ταυτοποίηση παθογόνων και μη παθογόνων μυκήτων.
ℹ️ ΧΡΟΝΟΣ ΖΩΗΣ: 120 ημέρες ℹ️ ΦΥΛΑΞΗ : 2 – 8* C
ℹ️ Ελάχιστη Παραγγελία: 10 x 60 mm ℹ️ Συσκευασία: 10 x 60 mm
⚠️Οι τελικές τιμές επιβεβαιώνονται με την λήψη του προτιμολογίου και ενδέχεται να αλλάξουν χωρίς ειδοποίηση. ⚠️Οι φωτογραφίες έχουν αποκλειστικά ενδεικτικό χαρακτήρα & ενδέχεται να διαφέρoυν από το πραγματικό προϊόν.
Βαμβακοφόροι στυλεοί ξύλινοι, 150mm, αποστειρωμένοι ανά ένας
Βαμβακοφόροι στυλεοί ξύλινοι, 150mm, αποστειρωμένοι ανά ένας , σε ατομική συσκευασία blister.
ℹ️ Ελάχιστη Παραγγελία: 100 ℹ️ Συσκευασία: 100
⚠️Οι τελικές τιμές επιβεβαιώνονται με την λήψη του προτιμολογίου και ενδέχεται να αλλάξουν χωρίς ειδοποίηση. ⚠️Οι φωτογραφίες έχουν αποκλειστικά ενδεικτικό χαρακτήρα & ενδέχεται να διαφέρoυν από το πραγματικό προϊόν.
Κρικοφόροι στυλεοί πλαστικοί (PP), 10μL , 5 Τεμαχίων
Κρικοφόροι στυλεοί πλαστικοί (PP), 1μL, αποστειρωμένοι, σε συσκευασία Peel-pack των 5 τεμαχίων.
ℹ️ Ελάχιστη Παραγγελία: 5 ℹ️ Συσκευασία: 500
⚠️Οι τελικές τιμές επιβεβαιώνονται με την λήψη του προτιμολογίου και ενδέχεται να αλλάξουν χωρίς ειδοποίηση. ⚠️Οι φωτογραφίες έχουν αποκλειστικά ενδεικτικό χαρακτήρα & ενδέχεται να διαφέρoυν από το πραγματικό προϊόν.
Σύριγγα – SΑFΕΤΥ A.T/G, Με Βελόνα LUΕR
Σύριγγα Safety AT/G με αποσπώμενη βελόνα, αποστειρωμένη με Αιθυλενοξείδιο, μιας χρήσης. Διάφανο πολυπροπυλένιο, μη τοξικό και μη πυρετογόνο. Βελόνα από ανοξείδωτο χάλυβα AISI 304 με τριπλή πλαγιοτομή , 3 μερών. Ατομική συσκευασία σε blister.
ℹ️ Ελάχιστη Παραγγελία:100 τεμ.(1ml - 2.5ml - 5ml - 10ml - 20ml) ℹ️ Ελάχιστη Παραγγελία:45 τεμ.(60ml) ℹ️ Το προιόν διατίθεται σε : 1 ml , 2.5ml , 5ml, 10ml, 20ml, 60ml.
Επιλογή
Αυτό το προϊόν έχει πολλαπλές παραλλαγές. Οι επιλογές μπορούν να επιλεγούν στη σελίδα του προϊόντος